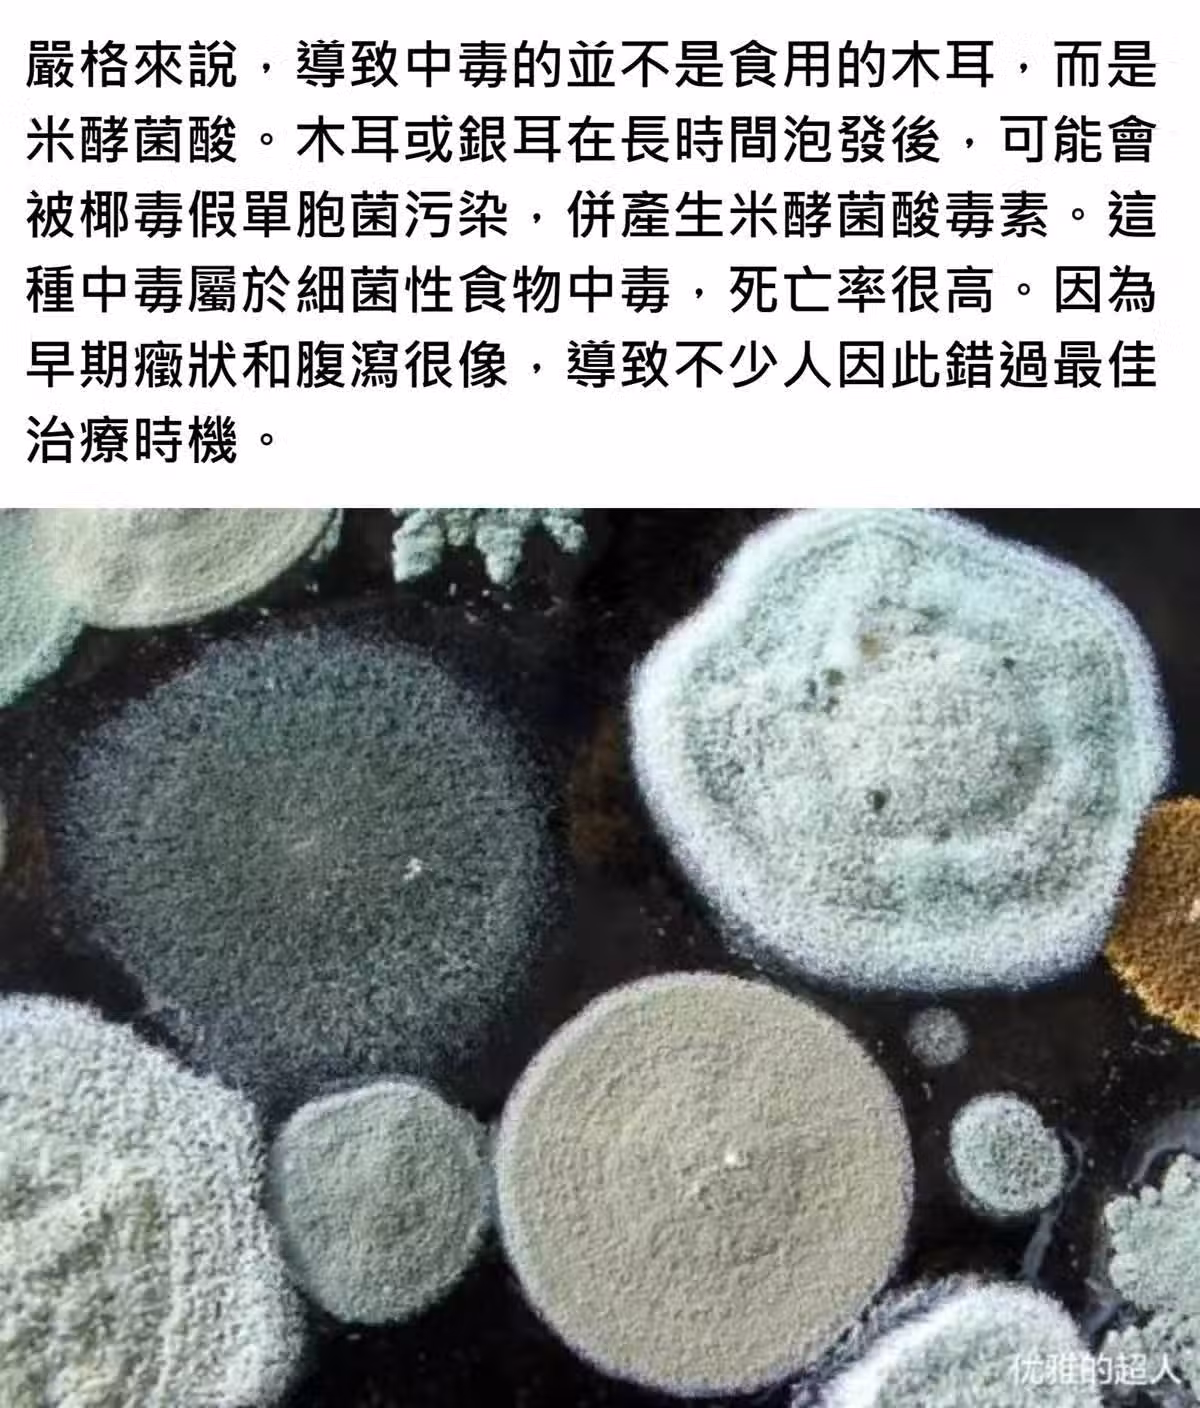

5/6
下一頁
女童嘔吐腹瀉後去世!醫院檢查無果,直到弟弟發燒「才知病因在餐桌上」:家長要引以為戒
5/6
未完待續,下一頁更精彩!
 幸山輪 • 36K次觀看
幸山輪 • 36K次觀看 幸山輪 • 1K次觀看
幸山輪 • 1K次觀看 喬峰傳 • 4K次觀看
喬峰傳 • 4K次觀看 呂純弘 • 1K次觀看
呂純弘 • 1K次觀看 李雅惠 • 360次觀看
李雅惠 • 360次觀看 幸山輪 • 730次觀看
幸山輪 • 730次觀看 幸山輪 • 320次觀看
幸山輪 • 320次觀看 幸山輪 • 810次觀看
幸山輪 • 810次觀看 老臘肉 • 1K次觀看
老臘肉 • 1K次觀看 李雅惠 • 230次觀看
李雅惠 • 230次觀看 李雅惠 • 190次觀看
李雅惠 • 190次觀看 呂純弘 • 610次觀看
呂純弘 • 610次觀看 李雅惠 • 220次觀看
李雅惠 • 220次觀看 喬峰傳 • 560次觀看
喬峰傳 • 560次觀看 老臘肉 • 4K次觀看
老臘肉 • 4K次觀看 喬峰傳 • 1K次觀看
喬峰傳 • 1K次觀看 奚芝厚 • 260次觀看
奚芝厚 • 260次觀看 許夢可 • 210次觀看
許夢可 • 210次觀看 舒黛葉 • 870次觀看
舒黛葉 • 870次觀看 喬峰傳 • 300次觀看
喬峰傳 • 300次觀看 幸山輪 • 150次觀看
幸山輪 • 150次觀看 喬峰傳 • 2K次觀看
喬峰傳 • 2K次觀看 幸山輪 • 330次觀看
幸山輪 • 330次觀看 呂純弘 • 5K次觀看
呂純弘 • 5K次觀看






















